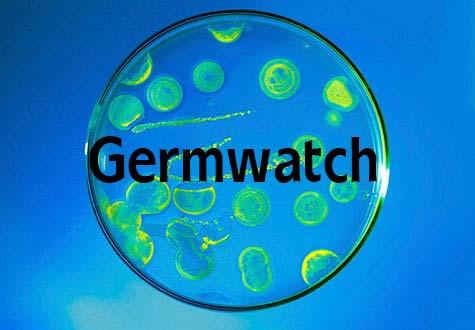
in Culpeper, seasonal allergies are starting to kick in

Germwatch: Warm Weather Brings Hand, Foot and Mouth Disease, Plus Ticks


Chances are, your kids love the vacations, pool trips and camps that come with summer. But for infants and kids in preschool, the recent warmer weather also means an increased risk of hand, foot and mouth disease.
This month, we talked to pediatrician Juli-Anne Wade, MD, who is seeing more of this virus in her patients at Augusta Pediatrics.
Hand, Foot and Mouth Treatment
Hand, foot and mouth is common in infants and preschool-age children, but adults can get it, too. It spreads through contact with saliva and stool. Frequent handwashing helps stop it from spreading to others.
The virus often starts with a mild fever, runny nose and congestion. Then mouth sores and a rash develop, usually on the hands and feet but sometimes all over the body. The rash varies but may look “pretty icky,” with crusted blisters, Wade says.
Hand, foot and mouth lasts around three to seven days. Kids are contagious until they stop getting new blisters.
Typically, parents should let the virus run its course and focus on keeping the child comfortable. Treat pain with children’s ibuprofen or acetaminophen.
Because the mouth sores tend to be the most uncomfortable, kids may become dehydrated. Take them to the doctor if they’re not urinating at least three times in a 24-hour period or if over-the-counter medication isn’t controlling their pain, Wade says.
Summer Safety: Preventing Weight Gain, Sunburn and Lyme Disease in Kids
You may have read that kids gain weight at a faster rate over the summer. Wade says it can go either way.
Kids who already struggle with weight sometimes actually lose pounds over the summer or at least maintain their weight. That’s because they’re more active at summer camp than they are during the school year. This can be a chance for them to discover new activities and build healthy habits for the school year.
But Wade says she worries about young teens who are home alone and have free reign for the first time. She recommends that parents:
- Talk to kids about healthy snacking and meals
- Avoid keeping lots of junk food in the house
- Talk to kids about activities they’re allowed to do, such as bike riding
Lyme Disease in Kids
Reported cases of Lyme disease have more than doubled in Virginia over the last 10 years, according to the CDC. Kids can get it too, although Wade says she doesn’t see many cases.
Black-legged ticks, also known as deer ticks, spread Lyme disease. If your kids are going hiking or are playing in a grassy field, avoid tick bites by:
- Covering exposed skin with long clothing and high socks.
- Using a bug spray. Look for something with a “family safe” label, which means it contains smaller amounts of insect repellant DEET than a “deep woods” formula. Follow the directions on the label.
Inspect the body for ticks afterward, including behind the ears and on the scalp. Learn more about preventing tick-borne illnesses like Lyme disease.
When kids get a tick bite, Wade recommends a doctor visit if the tick was on the body for more than two days or if the child has skin irritation. She’s particularly concerned about the characteristic red ring/bull’s eye rash that may develop around the bite.
Kids can also get a rash over their entire body or Lyme arthritis, where one joint, often a knee, becomes swollen and inflamed. This can happen months after the bite.
Since Lyme disease doesn’t show up on tests until several weeks after the bite, doctors will go ahead and prescribe antibiotics if they see the characteristic rash or arthritis.
Sun Safety
Finally, don’t forget sunscreen for kids ages six months and older. Wade suggests:
- Look for an SPF of at least 15 and ideally 30-50
- Regardless of SPF, re-apply every two hours or after swimming or sweating
- If you’re using the spray sunscreen, spray it on your hands first and then rub it into the skin
Chemical v.s. Mineral Sunscreen
Don’t use a conventional chemical sunscreen in babies under six months of age. They can absorb the chemicals through their skin, which can affect hormones, including testosterone levels in boys.
Looking For a Pediatrician?
Augusta Pediatrics is open seven days a week and is accepting new patients. Make an appointment:
For babies, avoid sunburn by dressing the baby in long, lightweight layers and a wide-brimmed hat, and stay in the shade. If that’s not possible, then you can use a small amount of mineral-based sunscreen, such as zinc oxide, on sun-exposed areas.
Some parents also prefer the mineral sunscreens for older children because of concerns about chemical absorption. These sunscreens may also be better for kids with sensitive skin.
Regardless, Wade reminds us that it’s always better to use the sunscreen you have than to go without.
The Germwatch series provides information on what’s going around in our community as well as popular reasons for primary care visits.
Subscribe to Healthy Balance
Get timely health and wellness tips from UVA Health experts. Plus, stories that will move you.